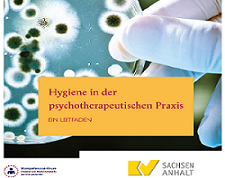

Portalweite Schnellsuche
Leitfaden "Hygiene in der psychotherapeutischen Praxis
Leitfaden "Hygiene in der psychotherapeutischen Praxis"
Das Kompetenzzentrum (CoC) Hygiene und Medizinprodukte der KVen und der KBV hat den Leitfaden "Hygiene in der psychotherapeutischen Praxis" erarbeitet.
Der Hygieneleitfaden versteht sich als Unterstützungs- und Serviceangebot für das praxisinterne Hygienemanagement. Er soll einen Überblick über alle Anforderungen an die Hygiene in der psychotherapeutischen Praxis verschaffen und vor allem konkrete Umsetzungsmöglichkeiten aufzeigen. Mit einer detaillierten Struktur und Untergliederung soll er gleichzeitig Informationsquelle und Nachschlagewerk für Einzelfragen der Hygiene sein.
Mit der Zielsetzung einer möglichst umfassenden Unterstützung greift er auch Hygienethemen auf, die nicht alle Psychotherapiepraxen betreffen: Den Umgang mit Medizinprodukten für Therapeuten, die Geräte in der Therapie einsetzen und den Arbeitsschutz für die Praxisinhaber, die Mitarbeiter beschäftigen. Die detaillierte Struktur und die Untergliederung ermöglicht es, die jeweils relevanten Themen zu identifizieren.
Wie ist der Hygieneleitfaden für die Psychotherapiepraxis aufgebaut?
Der Hygieneleitfaden beinhaltet drei Kapitel zu folgenden Themen:
- Hygienemaßnahmen in der psychotherapeutischen Praxis
- Medizinprodukte in der psychotherapeutischen Praxis
- Arbeitsschutz und Arbeitssicherheit in der psychotherapeutischen Praxis
Anhang (u. a. Mustervorschlag für einen Hygieneplan in der Psychotherapiepraxis)